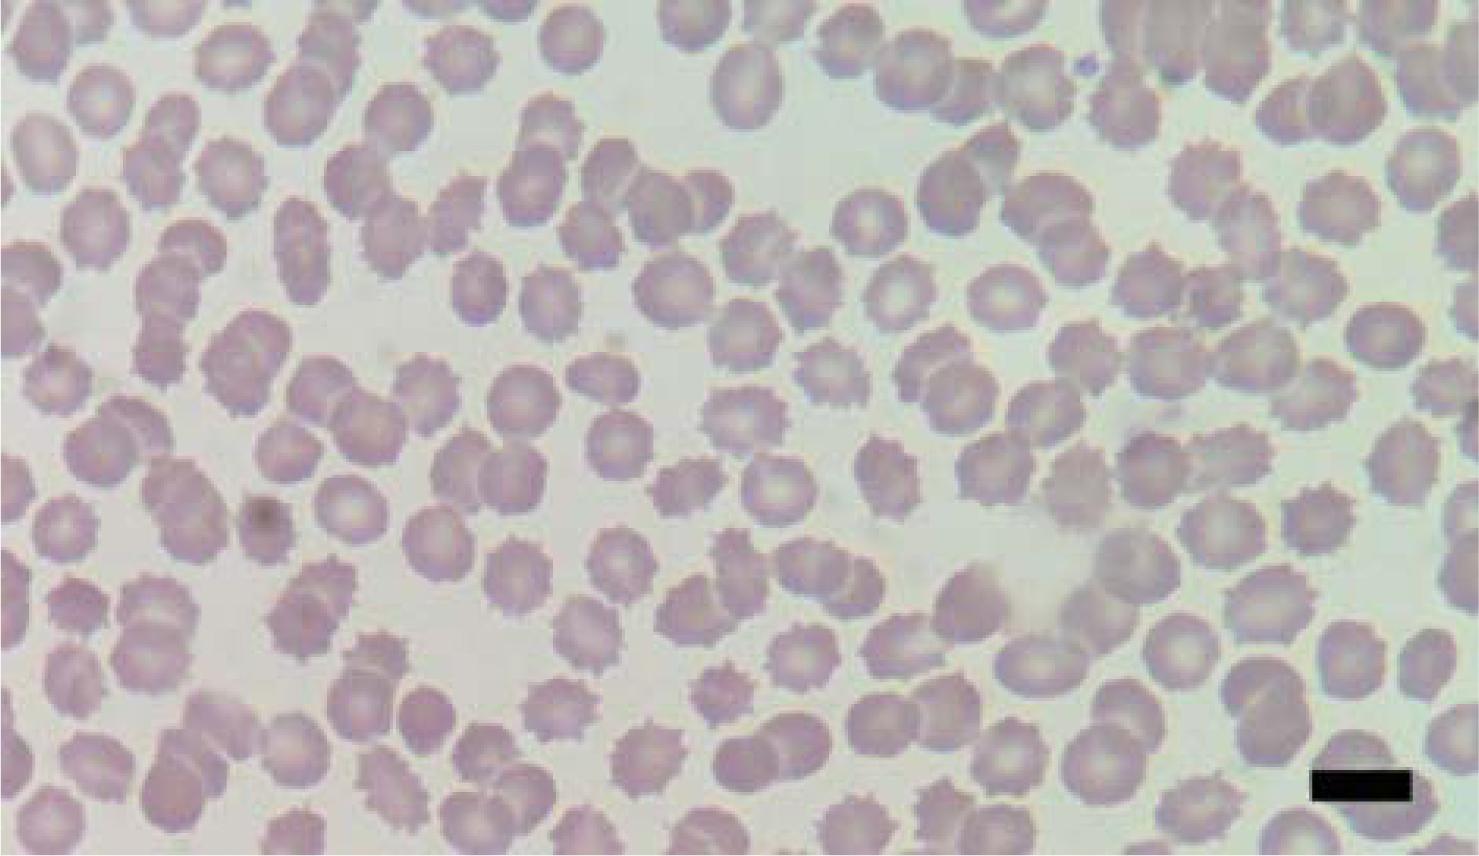

Dengue fever with varying severity is endemic in Thailand [1, 2, 3, 4]. Infection with dengue virus is often clinically indistinguishable from other tropical infections. Decreasing platelet counts and leukopenia are usually clues to the diagnosis [2, 3, 4]. Multiple studies demonstrated that these hematological variables are associated with severe dengue as early predictors. However, no valid cut-off point is yet established [5, 6, 7, 8].
Echinocytes are red blood cells with an altered membrane shape, which is deformed by surface spikes. They are easily visualized on peripheral blood smears (PBS) (Figure 1). Excessive ethylenediaminetetraacetic acid (EDTA) chelating agent concentration used during routine blood collection, chronic renal insufficiency, or echinocytogenic drugs, such as chemotherapeutics (Adriamycin), can sometimes result in echinocyte formation.
Peripheral blood smear demonstrating numerous echinocytes, among a few normal red blood cells (from patient 8 at defervescence (D0), Wright’s stain, bar 10 pm, original magnification × 100).
Transaminitis reflects acute liver injury and is a common finding in patients suffering from dengue infection, particularly in those with dengue hemorrhagic fever and dengue shock syndrome [7]. Additionally, serum high-density lipoproteins (HDL) decrease substantially during the critical phase of severe dengue, dengue hemorrhagic fever, and dengue shock syndrome compared with uncomplicated dengue fever [8]. Pathological sequelae of abnormal HDL in patients with liver disease, result in echinocyte formation [9]. However, to our knowledge, there are no case reports or studies regarding echinocytosis in patients who are suffering from dengue infection that relate to severity of disease.
We postulated that the liver injury and abnormal HDL levels associated with severe forms of dengue infection cause transient echinocytosis. Echinocytes may then appear in PBS under light microscopy before or during the critical phase of disease. We examined PBS for echinocytosis in patients suffering from dengue fever and its association with liver enzymes and clinical severity.
After review and approval of our protocol by the institutional review board of Mahasarakham University (approval No. 0065/2558), we conducted a retrospective cross-sectional study in our primary care clinic at Mahasarakham University Hospital with a community population of 65,301. We reviewed inpatient charts, out-patient records, and laboratory test results of patients admitted from August 15 to 31, 2015. All patients with dengue infection were tested with WHO Regional Office for Southeast Asia (SEARO) 2011 and WHO 2009 clinical criteria. To confirm patients as having dengue, we used a rapid immuno-chromatography test (SD Bioline, Standard Diagnostics, Korea). A positive result for dengue infection was noted when a dengue virus nonstructural protein 1 antigen (DNS1Ag), or IgM or IgG antibodies were detected in serum. Exclusion criteria were: (1) other bacterial or viral infection found by laboratory or clinical findings, (2) known liver disease documented by laboratory or clinical findings, and (3) if the data were incomplete.
Dengue with warning signs (DWS) and without (DWoS) were classified according to WHO 2009 criteria. DWoS included fever with body temperature (BT) ≥38°C and at least 2 of the following: aches and pains, nausea or vomiting, rash, white blood cell count (WBC) <5,000 cells/mm3, and positive tourniquet test. DWS matched DWoS criteria, but had additionally: abdominal pain, persistent nausea and vomiting, pleural effusion or ascites detected by plain radiography or ultrasonography, mucosal bleeding, lethargy, restlessness, liver enlargement of more than 2 cm, and a rising hematocrit with a rapid fall in platelet count. Dengue fever (DF) was defined according to the WHO SEARO 2011 revised guidelines with at least 2 of the following symptoms or laboratory findings: fever with BT ≥38°C, headache, retro-orbital pain, myalgia, arthralgia or bone pain, rash, WBC <5,000 cells/mm3, platelet count <150,000 cell/mm3, and hemorrhagic manifestations (including a positive tourniquet test). Dengue hemorrhagic fever (DHF) included all of the following symptoms or laboratory findings: acute febrile illness with BT ≥38°C for 2–7 days, hematocrit increases ≥20% compared with the baseline for lowest hematocrit, evidence of leakage by ultrasonography, plain radiography or low albumin level, mucosal hemorrhage or other internal organ hemorrhage, and platelet count <100,000 cell/mm3. Spontaneous bleeding differentiated DHF grade II from grade I. Alanine transaminase (ALT) was measured in international units per liter (IU/L), the highest values from each patient were included in the analysis.
All PBS were stained with Wright’s stain by qualified laboratory technicians. The quality of staining and artifacts were checked by a hematologist before complete evaluation of slides. The hematologist was blinded to the history of the patients. Quantity of echinocytes were categorized as rare (<10%), few (11%–15%), 1+ (16%–25%), 2+ (26%–50%), 3+ (51%–75%), and 4+ (76%–100%). At least 10 microscopic fields were inspected. An echinocyte was differentiated from an acanthocyte by the short and uniform shape of projections throughout the RBC membrane.
The days before and after defervescence (D0) are designated as D– and D+. A persistent fall of BT <38°C defined defervescence. PBS at D–1 and D0 from all patients were evaluated. If echinocytes were presented at either D1 or D0, the PBS at D–X and D+Y would also be examined, whereas D–X and D+Y were the days before D–1 and after D0. When no echinocytes were found, but found at D1 and D0, PBS at other days would not be inspected. If echinocytes appeared in the PBS, 5 PBS on the same day from other patients would be nonspecifically selected and reviewed as a quality control.
Descriptive statistics were used to report the study’s demographic and laboratory data (mean ± standard deviation (SD) and percentage). We used a Wilcoxon rank sum test to compare the means between two categorical groups. We then used a Fisher exact test to determine the probability of an association between echinocytes in PBS and severity of dengue infection. P < 0.05 was considered significant. We used SPSS for Windows, version 23 (IBM Corp, Armonk, NY, USA) for analyses.
Thirteen patients satisfied inclusion criteria (1 DHF grade I, 1 DHF grade II, 11 DF defined according to the WHO SEARO 2011 criteria; or as 7 DWS and 6 DWoS according to the WHO 2009 criteria). Five patients were excluded. The excluded patients lacked: a hepatitis viral profile (with the presence of echinocytes in 5), liver function (in 3), and antibiotics prescriptions (because of suspected bacterial coinfection in 1 patient). All patients were positive for DNS1Ag. Eight patients were included in the study, in which 7 were treated as in-patients and 1 as an out-patient. Seven patients were students; and 1 was an employee. There were 6 male and 2 female patients. Both female patients were in the DWoS group. All in-patients received 5% dextrose with normal saline as a maintenance fluid since admission. Five patients, including 2 patients in the DWS group were admitted at D–2; and at D1 and D3 in 2 other patients. Six patients were considered as being in the DWoS group, while only 2 patients were considered in the DWS group. The study also further categorized 1 patient as having DHF and 7 patients with DF. The mean age (SD) of the patients was 19 ± 2.28 years old (DWoS) and 19 years old (DWS). There was no significant difference in age between the groups (P > 0.99). Two patients in the DWS group had liver enlargement of more than 2 cm, with one experiencing abdominal liver tenderness on palpation and hemoconcentration ≥20%. The condition of all patients improved without any further complications.
All PBS were of good quality with no artifacts. Echinocytes were absent in all nonspecifically selected PBS. Cases of all included patients are summarized in Table 1. After exclusion of patients 9–13, 2 patients with echinocytosis were placed in the DWS group. The PBS of patient 8 at D0 is shown in Figure 1. No patient had a history of taking any medications before or during admission other than acetaminophen at 500 mg every 6 h. None of the patients showed hepatitis B antigen or hepatitis C antibody.
Echinocytes in the peripheral blood smears from our patients
| Patient | Echinocytes | Severity | ALT | |||||
|---|---|---|---|---|---|---|---|---|
| (1)D–X | D–1 | D0 | D+2 | (2)D+Y | WHO 2009 | WHO 2011 | (IU/L) | |
| 1 | No | No | DWoS | DF | 67 | |||
| 2 | No | No | DWoS | DF | 33 | |||
| 3 | No | Rare | Few | No | DWS | DF | 510 | |
| 4 | No | No | DWoS | DF | 18 | |||
| 5 | No | No | DWoS | DF | 15 | |||
| 6 | No | No | DWoS | DF | 34 | |||
| 7 | No | No | DWoS | DF | 11 | |||
| 8 | No | 3+ | 3+ | 1+ | No | DWS | DHF grade I | 199 |
| 9 | No | Few | 1+ | No | DWS | DF | (3)NA | |
| 10 | No | Rare | 3+ | (4)Referral | DWS | DHF grade II | NA | |
| 11 | Rare | Rare | Few | Rare | DWS | DF | NA | |
| 12 | Rare | No | No | DWS | DF | NA | ||
| 13 | No | No | Rare | No | DWS | DF | NA | |
Patients with warning signs had a mean (SD) alanine transaminase (ALT) level of 354.50 (219.91) IU/L, while the level was 29.67 (20.61) IU/L in those without. The lowest mean platelet count in the patients with warning signs was 33.5 (21.9) × 103 cells/mm3, while the count was 98 (66.1) × 103 cells/mm3 in those without. There was no significant difference in mean ALT level (P = 0.28) or the platelet count (P = 0.09) between patients with and without warning signs.
The presence of echinocytes at any examination during the study was significantly associated with DWS: 2 patients with echinocytosis in the DWS group and 6 patients without echinocytosis in the DWoS group (P = 0.04). No significant association was found between the DHF and DF group: 1 patient with echinocytosis in the DHF group, 1 patient with echinocytosis, and 6 patients without echinocytosis in the DF group (P = 0.13). When analysis included all patients, the results suggested that echinocytes found at any examination date was associated with DWS. This included 7 patients in the DWS group with echinocytes and 6 patients in the DWoS group with no echinocyte (P < 0.001). An echinocyte count of more than 2+ at D0 was associated with the DHF group (P = 0.013).
To our knowledge this is the first study to demonstrate a relationship between echinocytosis and dengue virus infection. The findings suggest that echinocyte presence in PBS may correlate with severe forms of dengue despite the small sample size of the present study. As controls, we examined the PBS for evidence of an EDTA effect on erythrocytes in PBS; but normal erythrocytes were observed among echinocytes, which made an EDTA effect unlikely, because EDTA would distort all erythrocytes. To mitigate the possibility of artifacts further, we examined the PBS of healthy adults. One hundred PBS revealed no echinocytes in healthy adults (staff and students). Moreover, none our patients had any history of taking any echinocytogenic drugs or any chronic renal insufficiency. Therefore, the presence of echinocytosis was most likely the result of dengue virus infection.
Patients with echinocytosis demonstrated the same patterns at or near the critical phase of dengue infection (classified according to both WHO 2009 and 2011 criteria [3, 4]). The cells were abundant at the critical phase of all DHF patients and in some DWS patients. Echinocytosis subsequently decreased during the convalescent phase in every patient. Our present data strongly suggest that acute dengue infection is a cause of echinocytosis because it is not previously present and disappears with recovery from dengue virus infection. To our knowledge, no previous study had reported this transient echinocytosis. A larger study of transient echinocytosis is warranted to strengthen our findings.
Transient echinocytosis can be found in peripheral blood smears of patients with dengue virus infection; particularly when there are severe clinical signs, and in dengue hemorrhagic fever. Examination of peripheral blood smears is simple and cost-effective, and available even in primary care clinics. The role of echinocytosis and its role as a simple and cost-effective predictor for severe dengue, warrants confirmation and further study.
Any day before D−1
Any day after D+2
NA, not available; ALT, alanine transaminase; WHO = World Health Organization Regional Office for Southeast Asia clinical criteria; DWS, dengue with warning signs; DWoS, dengue without warning signs; DHF, Dengue hemorrhagic fever; DF, Dengue fever; echinocytes were categorized as rare (<10%), few (11%–15%), 1+ (16%–25%), 2+ (26%–50%), 3+ (51%– 75%), and 4+ (76%–100%)
Referral because of moderate amount of right pleural effusion in chest x-ray image